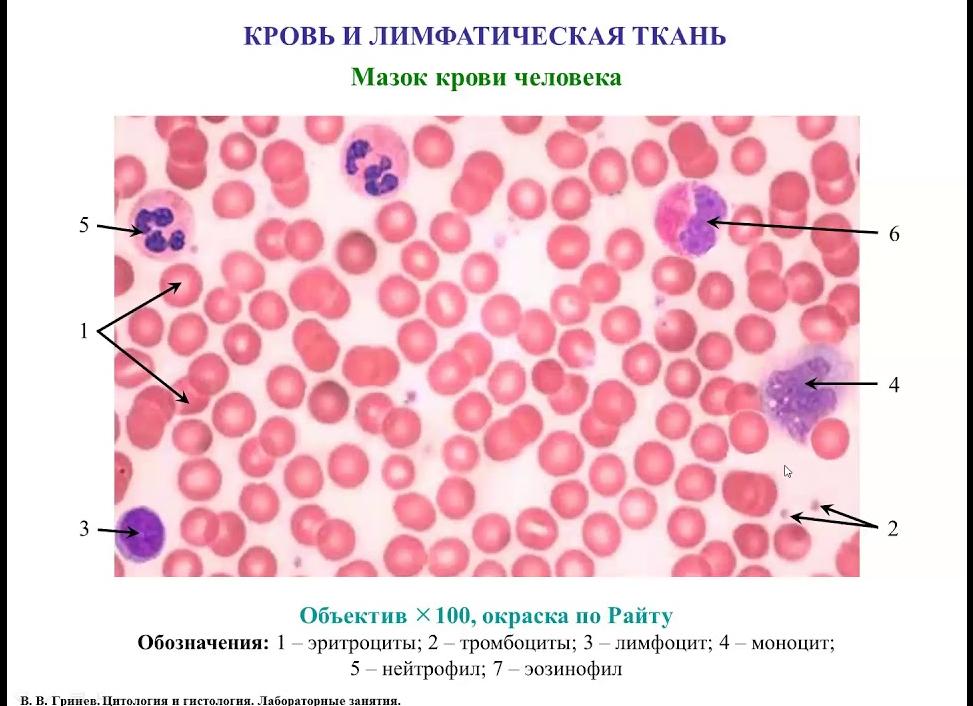
Мазок на гистологию

Мазок на гистологию
Главная » Мазок » Мазок на гистологию
Анализ на гистологию позволяет с максимальной четкостью определить, имеются ли в организме клетки или определенные образования негативного типа. Гистология способствует изучению в каком состоянии находится организм. Если сравнивать такой метод с другими исследовательскими методами, то становится понятно, что посредством этого анализа есть возможность получить максимально точные сведения. Надо отметить, что такой способ абсолютно безопасен, он может быть применен к людям, у которых имеются разные недуги, включая ибс.
На сегодняшний день человеческий организм исследуется самыми разными способами: различные исследования, сдача анализов. Однако, при всех достоинствах таких методов, иногда нет возможности постановить диагноз максимально точно, иногда для выявления патологий нужен иной метод. Именно таким способом является гистология. Про мазок на гистологию вероятно слышали многие, но вот что это такое точно, знают не все. А ведь с помощью такого метода можно внимательно изучить ткани и органы, таким образом патология будет выявлена своевременно. Подобный метод получил широкое распространение в гинекологии, а также успешно применяется в иных отраслях медицины. Так что нужно знать, что же такое анализ на гистологию, каким образом он делается.
Каким образом осуществляется анализ на гистологию?
Очень многие представления не имеют, что представляет из себя такая процедура, так как методика существенно отличается от других. Здесь многое отличается тем, что для каждого органа есть своя методика, поэтому здесь может быть использован мазок, метод срезов, тканевые пленки. Очень важно придерживаться утвержденного алгоритма, все правила исследования должны соблюдаться неукоснительно. Когда получен тканевый фрагмент, его следует поместить в этанол (может быть использован формалин), потом делается срез (он должен быть тонким) и его надо окрасить, для этого используются специальные вещества. Способов окрашивания тонких срезов есть несколько. Чаще всего применяются эозин, также широко используется гематоксилин. Такие вещества воздействуют на срезанную ткань, в результате чего цвет её меняется.
Если используется для окрашивания гематоксилин, то ткань приобретает синий цвет, а белки краснеют. После всех манипуляций готовый образец надо изучить посредством электронного микроскопа, необходимо выявить опасные клетки, которые могут стать причиной недугов. Есть и ещё один способ, когда тканевые срезы помещаются в специальный парафин, также может быть использован в этих целях бальзам. Для проведения исследования используются различные микроскопы, если использовать фазово-контрастный микроскоп, то можно рассмотреть образцы, которые с обычными микроскопами не рассмотришь. Забор тканевого образца производится пункционной иглой, также может быть произведена костная трепанация или проникновение в пути дыхания.
Что может показать анализ?
Подобный анализ осуществляется далеко не всегда. Есть определенные случаи, когда именно такой метод является приоритетным:
- чтобы понять, есть ли в человеческом организме раковые опухоли, именно по этой причина такой анализ применяется чаще всего. Если внимательно изучить ткани, то можно понять, есть ли вредоносные клетки;
- чтобы понять, почему имеется бесплодие;
- чтобы внимательно изучить в каком состоянии находятся женские органы мочеполовой системы;
- чтобы определить воспаление в органах системы пищеварения.
Сколько выполняется такой анализ?
Многих интересует вопрос, сколько нужно ждать результатов, однако здесь в каждом учреждении результат разный. Если говорить о средних показателях, то для получения результата нужно неделя-полторы после того, как взяты тканевые образцы. На срок также зависит, имеется ли в стационаре своя лаборатория, если есть, то и сроки соответственно меньше. Если же такой лаборатории в клинике нет, то из соседней лаборатории срок доставки может составить ещё пару дней.
Можно прибегнуть к экспресс-диагностике, её выполняют в операционной. То есть, когда проводится операция и возникает подозрение на наличие опухоли злокачественного типа, то срочно берется тканевый образец, который надо изучить в самое кратчайшие сроки. Если результат окажется положительный, то хирург выполняет операцию расширенного типа, именно по таким правилам удаляются образования онкологического типа. Но перед этим надо взять ещё анализ крови.
О результатах и расшифровке
Результат анализов человек получает в виде заключения, которое выполняется письменно. В таком заключении имеются сведения на предмет того, есть в тканях и клетках определенные нарушения или же их нет. Однако, неподготовленный человек далеко не всегда может самостоятельно расшифровать заключение, здесь необходимо соответствующее образование. Все написано на латыни, активно используются термины медицинского характера так что, узнать что показывает расшифровка узнать трудно.
Здесь сразу надо сказать, что норма, которая является нормальной, определяется врачом, не стоит ничего придумывать, считать, что ваша норма правильная или неправильная. Не стоит слушать других людей, которые искренне уверяют, что знают, какая норма должна быть, а какая норма имеет отклонения. Из-за этого могут быть уже психические срывы, к сожалению, так происходит довольно часто, особенно это опасно, когда пациент подвержен сердечным заболеваниям, например, ибс. Если гистология проводилась в государственной клинике, то о результатах подробно расскажет доктор во время приема, она же все расскажет, какая должна быть норма и соответствует ли ваша норма положенной.
Если все делалось в частной клинике, то заключение выдается на руки. Здесь есть немало информации, однако результаты подробно описываются в самом конце заключения. Многие, видя много информации, начинают беспокоиться, думая, что это описываются все выявленные у них патологии. На самом деле это не так, просто здесь подробно описываются все ткани. Так что ничего расшифровывать не нужно, пусть это сделает врач, который также объяснит, какие надо принимать профилактические меры или каким образом следует лечиться. Надо отметить, что результаты гистологии бывают и отрицательные и положительные, однако в любом случае в заключении не дается информации рекомендательного типа, такова специфика таких результатов.
Может ли быть ошибка в анализе?
Когда люди получают результаты анализов, в которых указано, что организм поражен злокачественной опухолью, испытывают надежду, что результаты ошибочные. Конечно, понять таких пациентов по человечески можно, но ошибки в гистологии, если и имеют место, то крайне редко. Не даром именно такой исследовательский метод является максимально точным, причем с его помощью можно не только определить, есть ли злокачественная опухоль, но и причины её образования. Конечно, определенный очень маленький процент ошибки имеется, врачи этого не отрицают. Но это может возникнуть при нарушении процедуры взятия тканевых образцов и проведения исследований, если все было сделано правильно, то ни о какой ошибке речи идти не может.
Однако, отчаиваться никогда не стоит, такие анализы для того и делаются, чтобы вовремя начать лечение. Причем, перед выбором лечебной терапии, учитывается общее состояние здоровья пациента, какие есть недуги, ибс или ещё что-то. Дело в том, что заболевания лечатся медикаментозными препаратами, которые могут иметь различные противопоказания, так что если человек болен ибс, список допустимых средств существенно сокращается. Тем не менее, если лечение выполняется правильно, пациент соблюдает все рекомендации врача, то можно вылечить многие недуги, в том числе и ибс и онкологические недуги, хотя порой это бывает очень трудно. При ишемической болезни сердца вообще нужно проявлять большую осторожность при назначении лечебной терапии.
Чем отличаются мазок на цитологию?
Цитология и ещё гистология являются одними из самых распространенных методов исследования патологий в организме. Такой вопрос, как чем цитология отличается, интересует многих, но прежде нужно сказать, что отличие цитологии заключается в том, что предметом её изучения являются живые ткани. То есть если при гистологии берется отдельный тканевый участок, то мазок на цитологию подразумевает изучение всех клеток, которые отработала шейка матки. Это основные отличия между гистологическими исследованиями.
Мазок на цитологию выполняется в целях получения сведений о недугах шейки матки или влагалищных нарушений.
Бывает, что мазка на цитологию бывает недостаточно для получения точной информации, тогда берется анализ крови. Здесь уже в дело может вступать гематология. Надо отметить, что анализ крови необходим, когда есть серьезные подозрения на раковые заболевания. Причем гематологический анализ может занять не мало времени.
Мазок на цитологию надо сдавать после того, как прекратились месячные. Если в организме есть сильные воспаления или период менструации, то мазок на цитологию не делается. За пару дней до такой процедуры, женщина должна прекратить вести сексуальную жизнь, недопустимо спринцевание и введение свечей, предназначенных для введения в вагину. Только после этого может делаться анализ на цитологию.
Такая процедура осуществляется так:
- пациента садится в кресло гинеколога, после чего доктор вводит ей во влагалище зеркало, которое позволяет получить доступ в каналу шейки матки;
- для мазка на цитологию используется шпатель специального назначения или специальная щеточка;
- после того, как врач произвел общий осмотр, мазок берется на месте, которое подвергнуто воспалению или просто подозрительно;
- материал, который получен таким способом, наносится на специальное стекло, после чего его можно внимательно изучать.
Вся эта процедура много времени не занимает, как правило на все уходит минут 15 и это включая гинекологический осмотр, так что в плане разницы во времени, то для цитологических исследований его требуется меньше.
ЛЕКЦИЯ О КРОВИ. НУЖНО ЗНАТЬ ВСЕМ!!!
Цитология. Лекция 8. Митоз. Окштейн И.Л.
B-лимфоциты и T-лимфоциты популяций CD4+ и CD8+
Нервная ткань. 6. Нервные волокна
Строение плазматической мембраны клетки
Что означает повышение лейкоцитов в анализе крови? — Доктор Комаровский
Зачетный тест по анатомии и гистологии. Коллоквиум по физиологии.
medistoriya.ru
Анализ на гистологию в гинекологии и что это такое
Когда назначается анализ на гистологию в гинекологии, что это такое, интересуются многие пациентки. Некоторых пугает это название, но оно не несет никакой угрозы женскому организму. Представленный тип диагностики используется давно и за этот промежуток времени успел себя зарекомендовать. Как проводится гистологическое исследование? О чем могут сигнализировать родинки? Каковы особенности проводимого анализа?
Что такое гистологическое исследование
Содержание
- 1 Краткая информация
- 2 Основные этапы
Краткая информация
Гистология — раздел науки, который занимается исследованием ткани. После изобретения микроскопа исследования клеточных структур заняли новый этап. Для того чтобы можно было исследовать строение и свойства многих тканей, материалы подвергали предварительной обработке. Многих женщин волнует вопрос, как связана гистология с гинекологией. Исследование проводится путем взятия мазка с шейки матки и ее канала. Лучше всего соблюдать строгую периодичность посещений — 2 раза в год. Полученный препарат будет использоваться в цитологическом исследовании. В течение нескольких дней в самом микропрепарате начинают проявляться ткани, характеризующиеся определенными свойствами: форма, строение, размер. Расшифровка позволяет определить потенциальные отклонения. В случае определения атипичных клеток можно говорить о первичной стадии развития онкологического процесса. Гистология отдельных тканей помогает установить точную клиническую картину. В этом случае материал для исследования берется посредством биопсии. Врачи отщипывают небольшую часть ткани от пораженного органа и начинают проводить дальнейшие исследования.
В случае обнаружения проблем с шейком матки делают ряд аналогичных процедур. Гистология целесообразна в следующих случаях:
- эрозия шейки матки;
- дисплазия;
- протекающие воспалительные процессы;
- родинки, кондиломы и т.д.
Основные этапы
Вышеописанный способ исследования давно применяется в гинекологии. Он является одним из конечных этапов комплексного обследования, после которого и устанавливается точная клиническая картина и ставится соответствующий диагноз. Главные преимущества представленного метода:
- Маточная ткань анализируется непосредственно, в отличие от ультразвукового или рентгеновского способа.
- Исследование взятого участка начинается сразу после забора. Используется специальный краситель, который позволяет подкрасить нужные части.
Результаты анализа могут быть известны в течение 1 дня. Для того чтобы клиническая картина стала полной, необходимо использовать биопсию. Взятие операционного материала может производиться в тот же день. Гистология считается универсальным способом диагностического исследования проблем, связанных с женской половой системой. Она позволяет предотвратить проблему на начальном этапе развития.
Биопсия шейки матки при эрозии
Исследование становится востребованным в случае замершей беременности, протекающего патологического процесса, инфицирования, кондиломы, родинки и др. Когда счет идет на дни, надо использовать этот метод. Он отличается своей результативностью и может применяться для точного отображения патологических процессов, которые могут выглядеть по-разному: новообразования, родинки, которые могут перерасти в злокачественные опухоли, кондиломы. Можно сформировать полную клиническую картину и на ее основании строить эффективно лечение. Исследование (биопсия) может быть назначено в том случае, когда искривляется поверхность шейки матки и в результате начинается формирование атипических сосудов.
В случае обнаружения папиллярного разрастания или присутствующего ацетобелого эпителия надо срочно проводить биопсию.
Гистология позволяет за день определить текущее состояние и поставить диагноз. Надо понять, что самолечение и самодиагностика могут привести только к ухудшению состояния. Проблема должна быть предупреждена на начальном этапе.
Автор: Е. Кубина
Оцените статью: (2 Голосов: 5,00 из 5) Загрузка…
Есть проблемы, запишитесь на прием к врачу.
analizypro.ru
Гистология шейки матки
Изучение через микроскоп подробного строения клетки органа или части ткани – составляет суть гистологического анализа. В гинекологии стандартной точкой отбора гистологической пробы служит шейка матки.
Причины проведения гистологии:
- Это единственная область матки, доступная для внешнего осмотра.
- Из-за анатомического положения шейка матки более часто подвержена воздействию повреждающих агентов (инфекционных, механических, вирусных).
- По характеру ткани шейки можно сделать заключение о структуре ткани матки в целом.
- Забор анализа на гистологию шейки матки делают во время обычного осмотра врача-гинеколога. Для исследования можно взять мазок или соскоб с шейки или цервикального канала.
Гистологическое исследование шейки матки
Гистология шейки матки является важной диагностической процедурой. Она охватывает как изучение строения клеток, полученных в результате мазка или соскоба, так и рассмотрение под микроскопом ткани, взятой методом биопсии. В каждодневной практике врачей исследования мазков и соскобов чаще обозначают понятием «цитологические исследования», а изучение образца биопсии – как «гистологию».
Соскоб производится специальным инструментом, практически не вызывая раздражающих ощущений у женщины. Материал соскоба размещается на особом стекле и проходит обработку для приготовления мазка, пригодного к просмотру под микроскопом.
Биопсия проводится специальной иглой. При необходимости биопсия может делаться с предварительным обезболиванием. Результаты гистологии шейки матки бывают готовы через двое-трое суток. Это время нужно для приготовления срезов ткани, изготовления мазков и расшифровки проведённого гистологического исследования.
По результатам гистологии врач может сделать выводы о состоянии эпителиальной ткани шейки матки: имеются ли изменения клеток и какой характер они носят (диспластический, эктопический, псевдоэрозийный и так далее). На основании этого анализа можно установить предварительный диагноз, который будет уточняться другими исследованиями.
Статьи по теме:
| Анализ на цитологию шейки матки
Цитологическое исследование шейки матки позволяет рассмотреть тип и строение клеток ее эпителия. Для этого делается соскоб, детально рассматриваемый под микроскопом: какие клетки, как выглядят, есть ли среди них атипичные. |
Если у женщины в мазке обнаружены гонококки, не стоит паниковать, лучше просто пересдать анализ. Некоторые методики исследований за венерические микробы принимают вполне безвредные кокки. А как точно обнаружить гонорею, мы вам расскажем. |
| Цитологическое исследование шейки матки
Каждой женщине раз в пятилетку положено проходить цитологическое исследование шейки матки. Этот анализ может спасти вам жизнь, вовремя заметив начинающийся рак. Но если у вас есть папилломы – проверяйтесь чаще! |
Во время гинекологического осмотра врач берет не только безболезненный мазок из влагалища, но и довольно чувствительный соскоб из уретры. Для чего нужен этот анализ и как к нему правильно подготовиться? |
womanadvice.ru
Гистология в гинекологии: что это такое, расшифровка анализа и как делают?
На приеме у врача пациент может столкнуться с необходимостью проведения гистологического исследования тканей. На сегодняшний день такое исследование широко применяется в медицине.
Гистология – это наука, изучающая ткани на клеточном уровне. В медицине под термином «гистология» понимают изучение срезов тканей под микроскопом на выявление болезнетворных очагов.
Общие показания для проведения исследования
Гистология в гинекологии стала просто незаменимой при диагностировании целого ряда женских болезней. Чаще всего к ней прибегают при проведении обследований женских внутренних половых органов. В результате анализа состояния клеточного аппарата можно делать заключения о глубине и тяжести выявленного заболевания. Проведение исследований на гистологию очень важно для постановки правильного диагноза и назначения корректного и своевременного лечения, так как такой вид анализа является наиболее подробным и достоверным.
Гистология в гинекологии назначается:
- при самопроизвольном выкидыше;
- при замирании беременности или при мертворождении;
- при подозрении на онкологию;
- при выявлении очагов воспалений в половых органах;
- после любого выскабливания;
- при бесплодии и невынашивании;
- при негативных результатах цитологии;
- при ациклических кровотечениях и во время менопаузы.
За двое суток до исследования на гистологию следует исключить интимную близость. Туалет половых органов проводить без использования моющих средств, не проводится спринцевание. Применение каких-либо лекарственных препаратов разрешено только по согласованию с врачом.
При выкидыше или при замирании беременности проведение гистологического исследования обязательно.
Замершей беременностью в акушерстве называют остановку развития плода на сроке до 28 недель. Это тот же самый выкидыш, но не произошедший. Причин нарушений течения беременности может быть множество, для предотвращения повторного случая при будущих беременностях проводят гистологию.
Чтобы сделать анализ, берут ткани плода, полученные после выскабливания, и подвергают их тщательнейшему изучению. Гистология практически всегда отвечает на вопрос о причинах смерти плода в утробе или самопроизвольного прерывания беременности. Но в определенных случаях требуется проведение дополнительного обследования.
к оглавлению ↑
Гистология при диагностике онкологических заболеваний
Онкологические заболевания на самых ранних стадиях своего развития протекают бессимптомно и не беспокоят пациента. При плановых осмотрах у врача-гинеколога можно выявить такое заболевание на его начальных этапах и приступить к лечению, когда оно еще эффективно. Врач, заметив некоторые характерные признаки, назначает проведение исследований органа методом гистологии.
Гистология помогает обнаружить не только наличие патологии, но и определяет характер новообразования: доброкачественное оно или злокачественное.
к оглавлению ↑
Гистология матки
К гистологии матки прибегают в случаях:
- продолжительного кровотечения;
- болей внизу живота неясного генеза;
- выявления бугристостей на стенках органа;
- новообразований снаружи или внутри органа или при выявлении других признаков раковой болезни.
Материал для проведения анализа отбирается напрямую из матки под действием местной анестезии. В условиях стерильности, при помощи гинекологических инструментов врач отщипывает кусочек ткани и потом отправляет ее в лабораторию.
Если по результатам гистологии обнаружены злокачественные клетки, то врачом принимается решение о назначении противораковой терапии. При выявлении в отобранных образцах здоровой ткани матки, делается заключение о наличии доброкачественного образования (миомы), и тогда процесс лечения или наблюдения будет совершенно иным.
к оглавлению ↑
Гистология шейки матки
Гистология шейки матки, проводимая для исследования органов половой системы женщин, позволяет предметно изучить ткани органа. Биопсия (отбор образца ткани для микроскопического исследования) проводится сразу после окончания месячного цикла или в самом его начале. Предварительно врач должен проверить репродуктивные органы пациентки на наличие инфекций.
Важно! При наличии инфекций гистология шейки матки противопоказана.
Проведение процедуры биопсии шейки матки не причиняет боли, но место отбора образца может начать кровоточить. Тогда медработник должен прижечь это место и наложить тампон. По результатам проведенной гистологии могут быть выявлены эрозия шейки матки, раковая болезнь, дисплазия и другие заболевания.
к оглавлению ↑
Гистология яичников
Ее делают при выявлении опухолей и уплотнений на яичниках. Для идентификации содержания кистозных образований и для определения типа опухоли производят отбор биологического материала непосредственно через стенку брюшины. В этих целях делают пункцию (прокол).
Отзыв нашей читательницы — Виктории Мирновой
Недавно я прочитала статью, в которой рассказывается о средстве Intoxic для вывода ПАРАЗИТОВ из организма человека. При помощи данного препарата можно НАВСЕГДА избавиться от хронической усталости, мигреней, стрессов, постоянной раздражительности, патологий ЖКТ и многих других проблем.
Я не привыкла доверять всякой информации, но решила проверить и заказала упаковку. Изменения я заметила уже через неделю: из меня начали вылезать паразиты и глисты. Я ощутила прилив сил, меня отпустили постоянные мигрени, а через 2 недели пропали совсем. И я почувствовала как мой организм восстанавливается после изнурительного истощения паразитами. Попробуйте и вы, а если кому интересно, то ниже ссылка на статью.
Читать статью —>
Иногда в гинекологии в процессе проведения обследований для выявления проблем со здоровьем половой системы женщин на гистологию отдают ткани эндометрия, участки слизистой оболочки цервикального канала, образцы жидкого содержимого образований в форме кисты во влагалище, полученных при помощи пункций.
к оглавлению ↑
Этапы проведения анализа и расшифровка его результатов
Чтобы сделать гистологический анализ, отбор проб должен производить только врач с опытом подобной работы, потому что от его профессионализма зависит конечный результат. Берутся образцы тканей с измененных участков.
- Вначале отобранный образец ткани оценивается визуально.
- Затем следует проводка – приготовление биопсийного материала специальным образом, обрабатывание тканей парафином. В результате получают гистологический (парафиновый) блок.
- Далее этот блок режется на тоненькие пластины толщиной в несколько десятых миллиметра (около одного микрона), на специальном аппарате – микротоме.
- Полученные пластины на следующем этапе проходят окрашивание специальными красителями, для получения контрастных изображений.
После проведения всех описанных операций образцы (готовые гистологические препараты) поступают на изучение к врачу-патоморфологу. Только данная технология дает стопроцентный ответ на вопрос: злокачественное образование или нет. На сегодня гистология является ключевым анализом при диагностировании онкологического заболевания.
Среднее время, которое затрачивается на проведение гистологического исследования тканей, обычно составляет около двух недель. Иногда ожидание в две недели может быть для пациента критичным, поэтому можно прибегнуть к экспресс-методу. В этом случае результат будет готов уже через 2-3 дня.
Получая результаты гистологии, пациентка зачастую пытается сама найти ответ о своем заболевании через знакомых или интернет. Правильная расшифровка полученных данных – это уже половина лечения. Доверьте расшифровку результатов анализа специалисту. Только квалифицированный врач сможет правильно оценить полученные данные и поставить правильный диагноз. Наличие непонятных слов, значений только заставляют нервничать.
В настоящее время практически нет неизлечимых болезней. Главное, вовремя обратиться к нужному специалисту, а не пытаться лечиться самому, чтобы не упустить драгоценное время.
А вы уверены, что не заражены паразитами?
По последним данным ВОЗ, более 1 миллиарда человек заражено паразитами. Самое страшное, что паразитов крайне сложно обнаружить. С уверенностью можно заявить, что абсолютно у всех есть паразиты. Такие обыденные симптомы, как:
- нервозность, нарушение сна и аппетита…
- частые головные боли…
- запах изо рта, налет на зубах и языке…
- изменение массы тела…
- поносы, запоры и боли в желудке…
- обострение хронических заболеваний…
Все это возможные признаки наличия ПАРАЗИТОВ в вашем организме. ПАРАЗИТЫ очень ОПАСНЫ, они могут проникать в мозг человека и там размножаться, что может привести к опасным болезням. Заболевания, вызванные паразитами, принимают хроническую форму.
Но возможно более правильно лечить не последствия заражения, а именно ПРИЧИНУ? Рекомендуем ознакомиться с новой методикой Елены Малышевой, которая помогла уже многим людям очистить свой организм от ПАРАЗИТОВ и глистов… Читать статью >>>
Дайте нам об этом знать — поставьте оценку (No Ratings Yet) Загрузка…
ginekologii.ru
Анализ на гистологию и мазок на цитологию расшифровка норма
Что представляет собой гистология в гинекологии
Так что же что такое гистология в современной гинекологии, что является причиной такого гинекологического исследования? Если говорить кратко, то речь идет о науке, предметом изучения которой являются то, каким образом построены ткани, какова их жизнедеятельность и каким образом они развиваются.
Для того, чтобы проводить гистологию в гинекологии есть целый ряд оснований:
- если прервана беременность любым способом, то есть речь может идти о таких явлениях, как аборт, выкидыше плода и замершей беременности. При этом изучается плацента, проводится эндометрия, чтобы выяснить причины выкидыша плода и определить в каком состоянии находится матка и её шейка. Гистология любого выкидыша плода производится очень часто;
- если было удалено новообразование или опухоль для того, чтобы выявить причины их появления, также нужно определить их тип (образование может быть злокачественным и доброкачественным);
- изучить состояние плодовых тканей, если есть подозрение на то, что беременность протекает с нарушениями;
- могут быть цели диагностического характера после того как было выскаблена матка. То есть гистология после выскабливания помогает поставить максимально точный диагноз, кюретаж выполняется абсолютно безопасными методами;
- определить качественный состав полипных тканей после того, как они удалены.
Гистология при замершей беременности
Не всегда беременность заканчивается благоприятно. Существуют причины, по которым происходит прерывание беременности.
Замершая беременность последнее время становится популярным явлением. Плод перестаёт развиваться, но выкидыш может не происходить до определённых моментов.
Чтобы понять причину, проводят анализ гистологии после замершей беременности. Делается эта процедура для выявления причины неприятной патологии сразу после чистки полости матки.
Исследуются ткани мёртвого зародыша, но в некоторых случаях специалисты могут взять для анализа маточный эпителий или ткани маточной трубы. Гистология плода после замершей беременности сможет показать реальную причину патологии, которую можно устранить с помощью медикаментов.
Овуляция яйцеклетки может произойти не только в матке, но и в маточной трубе. В этом случае вероятность развития плода и благоприятного исхода беременности равна нулю.
При обнаружении внематочной беременности, специалисты проводят специальную процедуру под названием лапароскопия. Из маточной трубы удаляют все лишнее и берут образцы тканей для проведения гистологического исследования.
Гистология после внематочной беременности сможет определить причину развития патологии. Чаще всего результаты показывают, что в маточных трубах происходил воспалительный процесс.
Но существуют и другие причины внематочной беременности, которые сможет выявить гистологическое исследование.
Может ли быть ошибка в анализе?
Очень многие представления не имеют, что представляет из себя такая процедура, так как методика существенно отличается от других. Здесь многое отличается тем, что для каждого органа есть своя методика, поэтому здесь может быть использован мазок, метод срезов, тканевые пленки.
Очень важно придерживаться утвержденного алгоритма, все правила исследования должны соблюдаться неукоснительно. Когда получен тканевый фрагмент, его следует поместить в этанол (может быть использован формалин), потом делается срез (он должен быть тонким) и его надо окрасить, для этого используются специальные вещества.
Способов окрашивания тонких срезов есть несколько. Чаще всего применяются эозин, также широко используется гематоксилин.
Такие вещества воздействуют на срезанную ткань, в результате чего цвет её меняется.
- чтобы понять, есть ли в человеческом организме раковые опухоли, именно по этой причина такой анализ применяется чаще всего. Если внимательно изучить ткани, то можно понять, есть ли вредоносные клетки;
- чтобы понять, почему имеется бесплодие;
- чтобы внимательно изучить в каком состоянии находятся женские органы мочеполовой системы;
- чтобы определить воспаление в органах системы пищеварения.
ПОДРОБНЕЕ ПРО: Настойка пиона в гинекологии — Lady Citytile
25.03.2014.
Очень радует, что в нашем городе есть такой замечательный медицинский центр. Мне дали направление на сдачу анализов на гистологию. Решила обратиться в ОНМЕД и не прогадала.
Я много начиталась в интернете насколько это серьезная процедура и как много зависит от квалификации, опыта и ответственности врача. Мне повезло, все прошло успешно.
После расшифровки результатов мне поставили точный диагноз и назначили эффективное лечение. Благодарю врачей медицинского центра за их золотые руки.
Людмила.
24.04.2014.
В медицинском центре ОНМЕД сдавала анализы на гистологию. Так получилось, что пришла без записи. Вежливые девочки меня выслушали и организовали все очень быстро. Процедура прошла быстро и безболезненно. Отдельное спасибо за оперативность. Кстати, цены здесь нормальные, не дерут три шкуры. Валентина.
Проведение гистологической процедуры
Такое исследование матки, как правило, является завершающим этапом комплексного осмотра. После него ставят окончательный диагноз. Основные преимущества гистологического обследования заключаются в том, что ткань матки изучают не через толщу других тканей, а непосредственно под микроскопом.
В гинекологии при проведении анализа на гистологию существует множество нюансов, которые обязывают доктора быть профессионалом и не совершать даже мелких ошибок.
Основным просчетом может стать забор ткани из менее пораженной области органа. Также при неправильном заборе можно взять не всю толщу эпителия.
В таком случае результаты будут полностью искажены, поэтому правильно сделать вывод о поражении матки врач не сможет.
Показания к проведению исследования
Причиной для назначения анализа могут стать боли внизу живота, ненормальный менструальный цикл, дискомфорт при сексе. Данный метод исследования используют при патологиях шейки матки, главного детородного органа.
Своевременно проведенное обследование даст шанс начать терапию на ранних этапах развития болезни. В некоторых ситуациях мазок на гистологию позволяет избежать оперативного вмешательства.
Диагностику шейки проводят при подозрении на наличие лейкоплакии, аномальных клеток, неровной поверхности тканей.
После проведения анализа можно обнаружить внематочную или замершую беременность, злокачественные или доброкачественные новообразования. Диагностика делается при хроническом воспалительном процессе в области эндометрия, ациклических маточных кровотечениях, гиперплазии, подозрении на рак слизистой оболочки матки.
Исследование назначают при обнаружении полипа, миомы.
Методика проводится для выявления различных отклонений и патологий. Гистологический анализ – это исследование эндометрия, изучение структуры плода.
Исследование позволяет изучить точное строение любой ткани. Диагностику назначают после выскабливания по разным показаниям, при любых отклонениях, выявленных путем обычного гинекологического осмотра репродуктивной системы женщины на кресле.
Стоимость гистологического исследования
Чем гистология отличается от цитологии
Предварительная запись на прием :
- Ветеринарные услуги
- Терапия
- Хирургия
- Стоматология
- Акушерство
- Вакцинация
- Чипирование животных
- Профилкатический осмотр
- Стационар
- Ветеринарная помощь на дому
- Диагностика
- Ультразвуковые исследования
- Клинический анализ крови
- Клинический анализ мочи
- Биохимический анализ крови
- Исследование крови на паразитов
- Цитология и гистология
- Бактериология и микология
- Исследование соскобов кожи
Цитологические и гистологические исследования новообразований
Гистология и цитология располагают разнообразным арсеналом как классических, так и современных методов, направленных на изучение строения и функций клеток, тканей и органов.
Оглавление:
- Чем гистология отличается от цитологии
- Цитологические и гистологические исследования новообразований
- Анализ мазка на цитологию и расшифровка гистологии
- Каким образом осуществляется анализ на гистологию?
- Что может показать анализ?
- Сколько выполняется такой анализ?
- О результатах и расшифровке
- Может ли быть ошибка в анализе?
- Чем отличаются мазок на цитологию?
- Чем отличатся гистология от цитологии?
- Что такое цитология?
- Анализ на цитологию
- Показания, подготовка, результаты
- Недостатки классической цитологии
- Жидкостная цитология
- Чем отличается цитология от гистологии
- Под стеклом Что такое гистология и цитология?
- Гистология VS цитология
- Гистологическое исследование
- Цитологическое исследование
- Комментарии
- Добавьте свой комментарий Отменить ответ
- Смотрите также
- Когда Рак распространяется
- Правда или вымысел? Самые распространённые заблуждения о раке
- Изменения тканей, которые не являются раковыми
- На игле Что такое химиотерапия?
- Анализ на цитологию: для чего и как его проводят
- Связанные болезни:
- Цитология и гистология — в чем отличие?
- Когда делается анализ на цитологию
- Какие материалы используются для анализа
- Жидкости
- Пунктаты
- Отпечатки
- Назначение цитологического исследования
- Цитологический анализ в гинекологии
- Проведение цитологического анализа в гинекологии
- Комментарии
- Цитология: что это такое, цель исследования, отличия от гистологии, показания к проведению анализа, преимущества и недостатки
- Мазок на онкоцитологию: используемые биологические препараты, подготовка и техника забора материала
- Цитологический анализ: возможные осложнения, расшифровка результатов, ориентировочная стоимость, дальнейшее обследование
- Чем отличаются гистология, цитология и биопсия?
- Гистология, эмбриология и цитология: в чем отличия?
- Чем отличается гистология от биопсии
- Разница между гистологией и цитологией
- Определение
- Сравнение
- Ваш дерматолог
- Отличие цитологического и гистологического исследований
- Область применения
- Способ получения материала
- Достоверность цитологического исследования
- Цитологическое исследование в онкологии
- Цитологическое исследование в акушерстве и гинекологии
- Цитологическое исследование в хирургии
Цитологические и гистологические методы исследования получают все большее распространение и в клинической диагностике различных заболеваний.
Цитологическое исследование опухолевых и неопухолевых процессов различных локализаций используется в качестве самостоятельного до лечебного метода морфологической диагностики или дополнительного к гистологическому. С помощью этого метода можно получать материал для исследования практически из всех тканей организма, в том числе и из внутренних органов. Цитологический анализ полученного материала часто имеет преимущества по сравнению с другими диагностическими тестами при распознавании рака в начальных стадиях его развития.
От цитологического гистологическое исследование отличается тем, что его проводят с образцом ткани пациента. Кусочек ткани можно получить, взяв биопсию, а также после проведения оперативного вмешательства . Гистологическое исследование – инвазивный метод, поэтому применяется только в случае уже развившегося заболевания.
Анализ мазка на цитологию и расшифровка гистологии
Каким образом осуществляется анализ на гистологию?
Что может показать анализ?
- чтобы понять, есть ли в человеческом организме раковые опухоли, именно по этой причина такой анализ применяется чаще всего. Если внимательно изучить ткани, то можно понять, есть ли вредоносные клетки;
- чтобы понять, почему имеется бесплодие;
- чтобы внимательно изучить в каком состоянии находятся женские органы мочеполовой системы;
- чтобы определить воспаление в органах системы пищеварения.
Сколько выполняется такой анализ?
О результатах и расшифровке
Может ли быть ошибка в анализе?
Чем отличаются мазок на цитологию?
Такая процедура осуществляется так:
- пациента садится в кресло гинеколога, после чего доктор вводит ей во влагалище зеркало, которое позволяет получить доступ в каналу шейки матки;
- для мазка на цитологию используется шпатель специального назначения или специальная щеточка;
- после того, как врач произвел общий осмотр, мазок берется на месте, которое подвергнуто воспалению или просто подозрительно;
- материал, который получен таким способом, наносится на специальное стекло, после чего его можно внимательно изучать.
Источник: https://medistoriya.ru/ginekologiya/analiz-na-gistologiyu.html
Чем отличатся гистология от цитологии?
Что может показать гистология что не обнаруживается при цитологии?
Необходимость проведения гистологии после того как уже сделана цитология не показавшая никаких атипичных клеток?
Цитология — наука, изучающая морфологию и физиологию клетки.
Гистология — наука, изучающая морфологию, жизнедеятельность и развитие тканей — системы клеток, объединенной общим происхождением и функциями.
Среди животных тканей, куда человек тоже относится, существует 4 типа:
- эпителиальная ткань
- соединительная ткань
- мышечная ткань
- нервная ткань
Количество же клеток значительно больше — одних только эпителиоцитов какое разнообразие! А соединительная ткань? И кровь, и кости, и хрящи, и жировая ткань — все это соединительная ткань! А ведь насколько они различаются во всем.
Когда берут материал на гистологическое исследование? При жизни — это биопсия. Посмертно — аутопсия. И то и то смотрит патологоанатом. Так что если вы сдавали хоть раз в жизни биопсию — значит частичка вас уже была в морге.
Гистологическое исследование покажет изменение ткани в системном плане. Ведь в ткани будут и сосуды, и нервы. Их изменения тоже имеют значения при патологии. К тому же ткань еще может быть покрыта биопленкой бактерий, а хорошо ли это или плохо от ситуации зависит.
Цитологическое же исследование больше для скринига. Ведь не будешь проводить у каждого инвазивную процедуру. В случае определения группы риска врач принимает решение о необходимости гистологического исследования. И цитологическое исследование помогает в выявлении группы риска и приближения к диагнозу.
Цитология может отвергнуть патологию при наличии одних нормальных клеток, подтвердить подозрение на заболевание-проводит ь лечение и наблюдение, углубить обследование, при наличии атипичных клеток, выявить и подтвердить патологию, поставить диагноз(конкретные клетки и признаки патологии на клеточном уровне). Гистология, уже, как вскрытие, обоснование(верифика ция) окончательного диагноза. При визуализации патологического места болезни возможны варианты с результатами цитологии. Клетки даст нормальные, а внешние изменения на фоне лечения будут оставаться прежние. С целью снятия сомнений может потребоваться гистология.
Гистология — это наука о тканях. Цитология — это наука о клетках. Гистология позволяет рассмотреть строение ткани в целом, а не только отдельные клетки. Кроме того разные анализы окрашиваются и анализируются по-разному поэтому они могут дополнять результаты друг друга. В вашем случае вы написали, анализы это каких тканей и по какому поводу, поэтому больше сказать нельзя.
Источник: https://www.bolshoyvopros.ru/questions/chem-otlichatsja-gistologija-ot-citologii.html
Что такое цитология?
Анализ на цитологию
Цитологический мазок — это очень быстрое, легкое, доступное и совершенно безболезненное исследование, позволяющее оценить степень отклонения клеток шейки матки. Мазок забирают в гинекологическом кресле в период осмотра пациенток. Сначала доктор с применением ватного тампона полностью расчищает поверхность шейки матки от выделений. Потом, используя особую щеточку, он берет необходимый материал для анализа и наносит его на специальное стекло, после чего содержимое относится в лабораторию и его исследуют под микроскопом.
Показания, подготовка, результаты
Для прохождения анализа на цитологию у женщин выделяют следующие показания:
Также следует отметить, что мазок следует сдавать сразу после окончания менструаций. Чтобы правильно подготовиться к походу в гинекологический кабинет, необходимо соблюсти несколько правил:
- Не мочиться перед процедурой в течение 2-3 часов.
Результаты, которые показывает анализ на цитологию, бывают двух типов:
- Нормальные, что говорит об отсутствии значимых патологий в шейке матки.
Недостатки классической цитологии
К сожалению, данный анализ не всегда дает точный результат. Этому есть ряд причин:
- Плоская щеточка не позволяет взять материал с полной поверхности органа.
Жидкостная цитология
В настоящее время у метода обычной цитологии с использованием мазка есть альтернатива — жидкостная цитология, которая показывает наиболее точные результаты. Главное отличие этого метода состоит в том, что клетки данного органа собираются с использованием наиболее усовершенствованной щеточки, которая помогает взять клетки со всех уголков шейки матки плюс из цервикального канала. Потом инструмент помещается в емкость с раствором и данные уходят в лабораторию.
- Клетки, помещенные в раствор, способны сохраняться до 6 месяцев. Учитывая эту особенность, возможно также сделать анализ на наличие вируса папилломы, и даже определить количество такого вируса, что имеет огромное значение при получении результата анализов жидкостной цитологии.
Чем отличается цитология от гистологии
Гистология — это наука, изучающая ткани организма. Гистологический анализ связан с цитологическим. С помощью него можно узнать точное строение различных тканей. Для гистологического исследования берутся не клетки, а ткани (хотя в некоторых случаях бывает достаточно мазка или отпечатка). Рекомендации о проведении анализа доктор дает индивидуально. Для того, чтобы получить результат, у специалистов уходит до 10 дней, но в редких случаях проводят экспресс-анализ в течение суток.
- Фрагмент ткани проходит специальную обработку для предотвращения гниения, а также обезвоживается для уплотнения.
Гистология определяет онкогинекологические заболевания и их симптомы. Анализ может быть взят со следующих органов: матка, шейка матки, яичники.
Компактный режим | Обычный режим
Любое воспроизведение материалов сайта без нашего письменного согласия ЗАПРЕЩЕНО!
Источник: https://vse-sekrety.ru/1122-chto-takoe-citologiya.html
Под стеклом Что такое гистология и цитология?
Зачастую люди, не имеющие медицинского образования, путают и смешивают понятия гистологии и цитологии. Для начала внесём ясность в эти термины.
Гистология VS цитология
Гистология – это раздел биологии о строении и структуре тканей живых организмов. Т.е. гистология исследует организм на тканевом уровне.
Цитология – по сути один из подразделов гистологии, изучающий клетки живых организмов, их строение, функционирование, процессы клеточного размножения, старения и смерти. Т.е. цитология – это исследование строения организма на клеточном уровне.
Упрощённо можно сказать, что цитология рассматривает отдельные клеточные элементы, а гистология позволяет оценить структуру ткани в целом. Поэтому, когда берётся биологическая ткань для исследований, то сначала проводится гистологическое исследование – изучение структуры ткани различными методами (существует более 2-х десятков основных методов), а затем ткань (особенно патологическая) исследуется на более глубоком уровне – на клеточном, т.е. делается цитологическое исследование.
Гистологическое исследование
Гистологическое исследование представляет собой взятие образца ткани пациента с помощью биопсии и применяется в тех случаях, когда заболевание находится на стадии развития. В некоторых случаях оно проводится уже после оперативных вмешательств, которые сопровождаются удалением какого-либо органа либо его части.
Анализ подразумевает некоторые временные затраты, так как перед тем, как часть ткани будет рассмотрена и тщательно изучена под микроскопом, её следует законсервировать, погрузить в парафин, выполнить ультратонкие срезы, специально окрасить, и только после выполнения всех этих необходимых процедур подготовленный материал можно изучать и рассматривать под микроскопом. Однако встречаются и такие случаи, когда сделать гистологическое исследование необходимо немедленно, например, в течение часа. Такая мера необходима для того, чтобы хирург имел точную осведомленность относительно того, стоит ли удалять или сохранять орган пациента ради сохранения его жизни.
Цитологическое исследование
Цитологическое исследование подразумевает собой оценку формы и состояния клеток и позволяет диагностировать доброкачественные или злокачественные новообразования на разных стадиях, а также неопухолевые поражения клеточной структуры. С помощью него можно получить материал для исследования практически из всех тканей в организме (это, в первую очередь, касается внутренних органов).
Анализ проводится прежде всего для того, чтобы получить точное подтверждение или, наоборот, опровержение наличия/отсутствия злокачественных новообразований. Этот метод довольно часто имеет преимущества по сравнению с другими мерами диагностики при распознавании раковых поражений на начальных стадиях развития. В ряде случаев он позволяет установить не только злокачественный характер заболевания, но и гистологический тип опухоли, что, в свою очередь, имеет огромное значение при прогнозировании заболевания и выборе эффективного метода лечения.
При наличии опухолевого процесса цитология также способствует наиболее раннему подтверждению злокачественного процесса. Положительный результат исследования нередко является главным морфологическим подтверждением клинического диагноза злокачественного характера и избавляет от необходимости проведения биопсии, которая довольно часто является нежелательной, поскольку очень часто существует опасность открытия кровотечения либо диссеминации опухоли (распространению раковых клеток из основного очага по кровеносных и лимфатическим путям по всему организму ). При этом отрицательный результат не всегда говорит от том, что злокачественный процесс отсутствует, так как взятый для исследования материал может оказаться не достаточно информативным.
На сегодня гистологические и цитологические исследования играют решающую роль в установлении точного диагноза у онкологических больных – они позволяют визуально определить все патологические изменения, которые происходят в организме человека на клеточном уровне.
Комментарии
Добавьте свой комментарий Отменить ответ
Смотрите также
Когда Рак распространяется
Рак, который распространился с места, где он впервые появился в другом месте тела, называется метастатическим…
Правда или вымысел? Самые распространённые заблуждения о раке
Источник: РИА Новости
Изменения тканей, которые не являются раковыми
Не каждое изменение в тканях организма – это рак. Однако некоторые изменения ткани могут развиваться…
На игле Что такое химиотерапия?
Что такое химиотерапия? Химиотерапия – это метод лекарственного лечения онкологических заболеваний, как правило, представляющий собой внутривенное…
Источник: https://xn--e1abxp8d.xn--p1ai/538/
Анализ на цитологию: для чего и как его проводят
Что такое цитологическое исследование? В каких случаях оно проводится? На эти и другие вопросы вы получите ответы в этой статье.
Цитологическое исследование — это изучение особенностей строения клеток, клеточного состава тканей, жидкостей и органов человеческого организма в норме и при патологических процессах с помощью микроскопа, Цель исследования — определить тип зафиксированных поражений, их доброкачественную или злокачественную природу.
Связанные болезни:
Цитология и гистология — в чем отличие?
Отличие цитологического анализа от гистологического исследования заключается в том, что изучаются клетки, а не срезы тканей. А значит, заключительные выводы делаются на основе изменений, происшедших в ядре, цитоплазме, ядерно-цитоплазменном соотношении, образования комплексов и структур клеток.
Когда делается анализ на цитологию
Цитологическое исследование применяется при:
- Профилактическом осмотре (скрининге)
- Уточнении или установлении диагноза заболевания
- Уточнении или установлении диагноза во время проведения операции
- Контроле во время и после проведения лечения
- Наблюдении динамики процесса или для раннего выявления патологических изменений
Какие материалы используются для анализа
Жидкости
Это могут быть жидкие образцы:
- мочи, мокроты или сока предстательной железы
- цереброспинальной и амниотической жидкости
- смывы с различных органов, взятые во время эндоскопии
- мазки шейки матки и мазки полости матки (цитологическое исследование мазков, цитологическое исследование шейки матки)
- выделения из молочных желез
- соскобы и отпечатки с эрозированных или язвенных поверхностей, свищей или ран
- жидкости из суставных и серозных полостей
Пунктаты
К ним относятся материалы, полученные с помощью аспирационной диагностической пункции, которая проводится с использованием специальной тонкой иглы.
Отпечатки
В данном случае речь идет об отпечатках с удаленных тканей, как, например, со свежей поверхности разреза ткани, удаленной во время операции или взятой для дальнейшего гистологического исследования.
Назначение цитологического исследования
Основным назначением цитологического метода исследования является получение ответа на вопрос об отсутствии или наличии у пациента, материал которого подвергся изучению, злокачественного новообразования. Этот метод позволяет более точно определять природу патологического процесса (доброкачественные и злокачественные опухоли), характер воспалительных, пролиферативных, реактивных и предраковых поражений.
Именно детальная морфологическая характеристика обнаруженного новообразования дает возможность выбрать наиболее обоснованный метод лечения. будь то хирургическое удаление новообразования, лучевая терапия, химиотерапия или их комбинация, в зависимости от строения опухоли, ее происхождения, степени атипии ее клеток и возможной реакции на лечение.
Цитологическое исследование, по сравнению с другими методами, имеет несомненные преимущества в выявлении начальных стадий рака. Этот метод исследования применяется в диагностике новообразований практически в любой из тканей и любого органа человеческого организма. Благодаря цитологическому исследованию удается обнаружить рак желудка, рак мочевого пузыря, рак легких,и других органов даже при отсутствии рентгенологических, клинических и эндоскопических проявлений и признаков.
Цитологический анализ в гинекологии
Мазок на цитологию берется в амбулаторных условиях во время гинекологического осмотра. В норме рекомендуется проводить такой анализ 1 раз в год, когда вы проходите профилактический осмотр у врача. Дополнительное цитологическое исследование могут назначить в случаях, если:
- имеются воспалительные заболевания, при которых появляется подозрение на наличие урогенитальной инфекции
- при исследовании причин бесплодия
- имеются жалобы на нарушения менструального цикла
- требуется определить хзарактер изменений вследствие длительного использования гормональной контрацепции
- при планировании беременности
- планируется оперативное гинекологическое вмешательство (выскабливание, установка внутриматочной спирали и пр.).
Проведение цитологического анализа в гинекологии
Лучше всего, если забор материала происходит надень менструального цикла. За 2 суток до процедуры следует воздерживаться от половых контактов, спринцевания, пользования контрацептивными или медпрепаратами местного действия. Около 2 часов до процедуры не следует также мочиться.
Соскоб (забор материала) из шейки матки производят с помощью специальной стерильной щеточки, после того, как врач введет гинекологическое зеркало и зафиксирует шейку матки. Как правило, это делается дважды — с места, расположенного ближе к матке и затем к вульве. Полученный материал наносят на предметное стекло, подсушивют и фиксируют с помощью специальных растворов. Часто, чтобы ускорить процесс получения результата, женщины сами доставляют материал в лабораторию для исследования.
Сама процедура производится совершенно безболезненно и очень быстро — не болеесекунд. После нее иногда может наблюдаться небольшое кровомазанье, которое проходит в течение суток. Обычно такое бывает при наличии у женщины каких либо воспалительных процессов.
Инструкции к лекарствам
Комментарии
Войти с помощью:
Информация, опубликованная на сайте, предназначена только для ознакомления. Описанные методы диагностики, лечения, рецепты народной медицины и т.д. самостоятельно использовать не рекомендуется. Обязательно проконсультируйтесь со специалистом, чтобы не нанести вред своему здоровью!
Источник: https://www.likar.info/onkologiya/articleanaliz-na-tsitologiyu-dlya-chego-i-kak-ego-provodyat/
Цитология: что это такое, цель исследования, отличия от гистологии, показания к проведению анализа, преимущества и недостатки
Онкологические заболевания органов мочеполовой системы с каждым днем диагностируют у все большего числа представительниц прекрасного пола. Однако с появлением новых лекарственных препаратов и терапевтических процедур излечение рака вполне реально.
Но прогноз патологии во многом зависит от того, на какой стадии заболевания был начат прием медикаментов. Поэтому одним из залогов успешного лечения служит ранняя диагностика. Однако при рассмотрении бланка назначений врача, возникает вопрос, цитология — что это такое?
В гинекологии и других отраслях медицины так именуют один из методов исследования клеточной структуры для выявления специфических для злокачественных новообразований изменений. В широкую клиническую практику этот анализ ввел греческий врач Джордж Папаниколау в середине прошлого столетия. С тех пор цитологическое исследование клеток шейки матки получило название ПАП-теста.
Его основной целью служит выявление атипии, иными словами, клеток, или уже подвергнувшихся злокачественной трансформацией, или имеющих все предпосылки к подобным изменениям. Причины развития таких нарушений до конца неизвестны.
Однако факторами повышенного риска их возникновения служат:
- наследственная предрасположенность;
- инфицирование вирусом папилломы человека (ВПЧ), если он протекает с образованием остроконечных кондилом в области половых органов;
- частые воспалительные поражения шейки матки и урогенитального тракта;
- плохие результаты обследования на флору влагалища, выявление повышенных концентраций патогенных бактерий, сравнительно недавно была доказана связь хронических часто рецидивирующих вагинозов с развитием атипии;
- частые венерические инфекции;
- первые роды в слишком раннем возрасте (до наступления совершеннолетия).
Кроме того, проведение анализа на цитологию показано таким категориям женщин:
- бесплодие;
- хроническое невынашивание беременности;
- подготовка к зачатию;
- частые рецидивы генитального герпеса;
- периодически возникающие симптомы нарушения бактериальной флоры влагалища;
- прием оральных контрацептивов или других гормональных препаратов;
- злокачественные новообразования различной локализации;
- период менопаузы;
- видимые изменения структуры шейки матки при гинекологическом осмотре при помощи зеркал;
- кровянистые выделения из влагалища, не связанные с месячными;
- предстоящая установка внутриматочных средств контрацепции.
Степени атипии соотносят с результатами ПАП-теста. Так, все возможные изменения строения клеток делят на несколько стадий:
- Первая. Какие либо нарушения структуры полностью отсутствуют.
- Вторая. Означает, что в ходе исследования были выявлены клетки с патофизиологическими признаками воспалительного процесса. Женщине рекомендуют провести дальнейшую диагностику для определения возбудителя и причины инфекции.
- Третья. Исследование демонстрирует начальные изменения клеточной структуры. Это еще не означает рак, но указывает на высокий риск его развития. Для подтверждения дополнительно показана гистология и ряд других анализов. Дальнейшую диагностику проводят на основании полученных результатов.
- Четвертая. Возникают первые признаки злокачественной трансформации клеток. Как правило, при выявлении онкологии на данном этапе прогноз благоприятен. Однако для подтверждения диагноза показаны дополнительные исследования.
- Пятая. Результаты цитологии однозначно указывают на злокачественное перерождение тканей.
Некоторые пациенты путают цитологическое исследование с гистологическим. Это неудивительно, так как точная разница между этими методами проведения анализа известна врачам узкой специализации. В двух словах, гистология подразумевает исследование и осмотр подготовленного соответствующим образом среза тканей. Цитологический анализ — это обследование отдельных клеток на предмет патологических изменений.
В результате применения ПАП-теста смертность от рака шейки матки только в США снизилась почти на 70% (в соответствии с данными, приведенными на конец 1980-х). Однако существенным недостатком этой методики проведения анализа является высокая частота ложноотрицательных результатов (до 50%). Такую вероятность ошибки связывают с нарушением технологии забора проб, разрушения клеток и попадания посторонних примесей в процессе переноса биологического материала на предметное стекло.
Но медицинская наука не стоит на месте, и в настоящее время ПАП-тест проводят с использованием методов жидкостной цитологии. Суть этого способа состоит в том, что после взятия пробы материал помещают не на стекло, а в специальный раствор реагентов. Запечатанную пробирку отправляют в лабораторию для дальнейшего исследования.
Эта жидкость защищает материал от бактериальной инвазии, полностью сохраняет морфологические свойства клеток, создает оптимальные условия для дальнейшей транспортировки. В клинической лаборатории препарат подвергают обработке в центрифуге для удаления крови и инородных веществ. Затем специалист готовит цитологический препарат, в котором клетки располагаются на предметном стекле равномерно, тонким слоем.
В современных лабораториях для проведения жидкостной цитологии нередко используют автоматизированные системы, чтобы исключить вероятность ошибки из-за человеческого фактора.
Мазок на онкоцитологию: используемые биологические препараты, подготовка и техника забора материала
Материалом для проведения дальнейшего цитологического исследования служат:
- Биологические жидкости. Для диагностики рака шейки матки используют редко. Подобные образцы получают в результате массажа простаты (из уретры выделяется сок), обработки внутренних органов в ходе диагностических малоинвазивных операций. Для определения патологий респираторного тракта для анализа берут мокроту. В некоторых случаях возможно исследование мочи.
- Пунктаты. Материал получают в результате проведения диагностической пункции, для чего применяют соответствующие иглы. В зависимости от показаний проводят забор суставной, спинномозговой, у беременных амниотической жидкости, клеток новообразований, мышечной ткани внутренних органов, оболочек сердца.
- Отпечатки и соскобы. В данном случае биологический материал получают при прикладывании предметного стекла или соскабливании участков тканей из открытой раны при проведении хирургической операции, шейке матки в ходе биологического осмотра, язвам, свищам.
При обследовании на предмет выявления рака шейки матки берут мазок на онкоцитологию.
Доктора рекомендуют записываться на анализ через 1 — 2 дня после прекращения менструации. Но для получения достоверных результатов к проведению обследования необходимо правильно подготовиться:
- за 2 — 3 дня не проводить спринцевания влагалища, а просто подмываться с применением соответствующих средств для интимной гигиены;
- за трое суток до обследования прекратить использование различных препаратов в виде мазей, суппозиториев, тампонов, спермицидов, предназначенных для введения во влагалище;
- за 3 — 4 дня до анализа необходимо строго воздерживаться от сексуальных контактов;
- за 2 — 3 часа до визита к врачу не посещать туалет.
При пероральном приеме каких либо лекарственных препаратов, обладающих антибактериальным, противовирусным или фунгицидным эффектом необходимо сообщить об этом врачу до проведения цитологического исследования.
Забор материала для выполнения анализа производят следующим образом:
- Женщину просят пересесть на гинекологическое кресло.
- Для обеспечения доступа в шейке матки доктор использует расширитель.
- При помощи специального инструмента, который внешне напоминает небольшую щеточку, врач делает соскоб с поверхности шейки матки и цервикального канала. В некоторых случаях (по показаниям) доктор использует аспиратор, предназначенный для получения слизи из цервикального канала.
- Полученный образец помещают в специальную пробирку и соответствующим образом маркируют.
Нередко в процессе взятия материала для проведения цитологического исследования, гинеколог также делает мазок для анализа на состав смешанной бактериальной флоры влагалища, выявления возбудителей венерических инфекций. В настоящее время для облегчения процедуры взятия образцов и расшифровки полученных данных гинекологи применяют готовые тест-системы ThinPrep PAP Test или SurePath PAP Test. Использование последнего рекомендовано американской ассоциацией FDA, так как в ходе клинических исследований он показал более достоверные результаты.
Цитологический анализ: возможные осложнения, расшифровка результатов, ориентировочная стоимость, дальнейшее обследование
При соблюдении техники забора материала и подготовки к проведению обследования риск осложнений минимален. Процедура безболезненна, возможен лишь легкий дискомфорт. В единичных случаях (при наличии инфекции на слизистом эпителии влагалища) возможно рецидив бактериального вагиноза.
Результаты цитологического анализа представлены в виде латинской аббревиатуры. Обозначает она следующее:
- NILM 1, какие-либо нарушения отсутствуют;
- NILM 2 (также может стоять пометка reactive), подобный результат означает наличие признаков острого воспалительного процесса;
- ASC — US и H, эти буквы свидетельствует о присутствии инфекции, если есть пометка Squamous atypia NOS точный возбудитель патологии неизвестен, если вместо последних литер указаны KA, речь идет о ВПЧ;
- L и Н SIL (иногда обозначают CIN 1 и 2) , соответствуют легкой и средней степени дисплазии, обычно в бланке расшифровки указаны парой, что свидетельствует об отсутствии выраженных изменений, однако следует обратить внимание на предрасположенность к их появлению;
- Н SIL и CIS (в некоторых бланках присутствует аббревиатура CIN 2 и 3). Обозначает среднюю и тяжелую степень дисплазии клеток шейки матки;
- СА (иногда указывают Squamous cell carcinoma), такой результат свидетельствует о наличии признаков рака.
Эти показатели можно условно разделить на несколько классов. Первый диагностируют у совершенно здоровой женщины. Второй является одной из разновидностей нормы и обычно указывает на наличие какого-либо инфекционного воспаления.
Третий класс служит поводом для дальнейшего обследования, так как в данном случае выявляют тенденцию к началу злокачественных изменений. Четвертый можно отнести к фактически предраковым состояниям, а пятый ставят при наличии атипичных клеток. Иногда в бланке расшифровки анализа указывают нулевой класс, что свидетельствует о непригодности образца для проведения обследования.
Однако даже положительный результат цитологии не означает точного диагноза рака. Для подтверждения назначают еще ряд обследований, а именно:
- кольпоскопию;
- гистологию (биопсию);
- анализ крови на наличие специфических маркеров;
- исследования на канцерогенные вирусы, СПИД;
- УЗИ и томографию органов малого таза.
Но и при отрицательном результате анализа на цитологию необходимо проводить повторное обследование раз в год, особенно если присутствуют факторы риска возникновения онкологического процесса.
Цитологический анализ можно сделать в любой современной лаборатории. В некоторых случаях лаборант не обладает достаточными навыками для забора биологического материала, поэтому пациенту выдают готовые пробирки с реагентом. Доктор берет нужный образец, помещает его в лабораторную посуду и отправляет на исследование.
Выполняется анализ около 8 — 10 дней. Некоторые клиники за дополнительную плату предоставляют возможность получения результатов в более короткие сроки. Стандартная стоимость жидкостной цитологии колеблется в пределах 1500 рублей.
Расшифровку результатов исследования проводит гинеколог. На основании полученных данных он назначает соответствующую терапию или направляет пациентку на дополнительное обследование.
В целом, цитологический анализ является высокочувствительным, безопасным и точным методом ранней диагностики злокачественных преобразований в шейке матки. Подобное исследование позволяет выявить патологию на начальном сроке и быстро начать терапию. Это значительно повышает вероятность благоприятного исхода онкологического заболевания, снижает уровень лекарственной нагрузки, помогает избежать хирургического вмешательства. Доктора рекомендуют всем женщинам старше 35 лет сдавать этот анализ ежегодно.
Помните, что самолечение опасно для вашего здоровья! Обязательно проконсультируйтесь с лечащим врачом! Информация на сайте представлена исключительно в популярно-ознакомительных целях и не претендует на справочную и медицинскую точность, не является руководством к действию.
Источник: https://med88.ru/zppp/citologija/
Чем отличаются гистология, цитология и биопсия?
Очень часто на просторах интернета можно встретить вопрос про разницу биопсии, цитологии и гистологии. Вроде бы все эти термины связаны с наукой и исследованием тканей и применяются в современных обследованиях для обнаружения раковых и других опасных клеток. Но в чём же отличия?
Гистология, эмбриология и цитология: в чем отличия?
В современной медицине часто применяется гистологическое исследование, которое с почти 100% точностью позволяет определить наличие опасных процессов в организме человека.
Гистология по своему определению является наукой по изучению развития и строения тканей различных органов и систем человеческого организма.
Эмбриология – наука, изучающая появление зародыша и его последующее развитие, образование тканей.
Цитология является наукой, изучающей живые клетки. С помощью этой науки происходит изучение развития и строения клеток, их функций и процессов размножения. Цитологические исследования также помогают при постановке точных диагнозов и определения методов лечения. Если про эмбриологию все ясно, то чем отличается гистология от цитологии не совсем понятно.
Отличие цитологии и гистологии заключается в том, что в первом случае изучаются клеточные элементы отдельно, а во втором – структура ткани в целом.
Другими словами, когда проводится забор образца для дальнейшего изучения исследования, сначала рассматривается ткань, а при обнаружении патологии – отдельные клеточные структуры. В некоторых случаях цитологическое исследование проходит отдельно, без гистологического. Что точнее, цитология или гистология, сказать сложно. Эти современные исследования нередко дополняют и заменяют друг друга, и позволяют точно поставить диагноз при подозрении возникновения раковой опухоли и других опасных заболеваний. В некоторых случаях нет необходимости в проведении гистологического исследования, и вполне достаточно цитологического. Например, для обнаружения эрозии матки берётся мазок из влагалища.
Чем отличается гистология от биопсии
Многие путают понятия «биопсия» и «гистология», но различия имеются значительные. Отличие биопсии и гистологии заключается в том, что это совершенно разные определения. Биопсия – процедура по взятию необходимого образца ткани. А гистология занимается дальнейшим изучением и исследованием взятого образца. Другими словами, для проведения гистологии образцы тканей берутся методом биопсии. Причём биопсия может проводиться разными способами: под местным или общим наркозом при оперативном вмешательстве или с помощью пункционной иглы без дополнительного обезболивания.
Источник: https://detstrana.ru/article/roditeli/zdorove/chem-otlichayutsya-gistologiya-tsitologiya-i-biopsiya/
Разница между гистологией и цитологией
Гистология и цитология могут многое прояснить, когда дело касается чьего-либо состояния здоровья. Людям, далеким от медицины, не всегда понятны данные термины. Возникает резонный вопрос, чем отличается гистология от цитологии. Попытаемся в этом разобраться.
Определение
Гистология – дисциплина, посвященная изучению тканей разнообразных организмов, в том числе человеческого. Так же называется сам процесс исследования названного биологического материала.
Цитология является наукой о том, что составляет основу строения всего живого, то есть о клетках. Это же слово означает метод, предполагающий исследование подобных структурных единиц в рамках лаборатории.
Сравнение
В каждом случае есть свой объект рассмотрения, в чем и заключается главное отличие гистологии от цитологии. Так, первое из этих понятий имеет отношение к тканям, их строению и выполняемым функциям. Цитология же ориентирована на изучение структур меньшего масштаба – клеточных.
Чтобы произвести гистологическое исследование, необходимо сначала изъять фрагмент нужной ткани из организма. Для этого может потребоваться проведение биопсии. Иногда же забор осуществляется одновременно с оперативным вмешательством. Добытый биологический материал подготавливают в несколько этапов, а затем полученный препарат тщательно изучают под микроскопом. Результаты будут основанием для постановки диагноза.
В чем разница между гистологией и цитологией? В том, что первый метод является инвазивным и обычно применяется, когда болезнь уже дала о себе знать. Между тем цитология осуществляется без какого-либо травмирования организма. Однако эта процедура позволяет распознать патологию, которая только зарождается, еще при отсутствии настораживающих симптомов. В первую очередь это касается такого заболевания, как рак.
Простейшее цитологическое исследование предполагает взятие мазка, его размещение на стекле и подсушивание, после чего материал окрашивают и рассматривают при большом увеличении. Выводы о развитии заболевания в этом случае делаются на основе замеченных изменений в клеточной структуре.
Два рассмотренных исследования нередко проводятся друг за другом: сначала изучается в целом ткань, а затем выполняется более глубокий, клеточный, анализ материала. Иногда же нет необходимости в гистологическом вмешательстве и можно обойтись только цитологией. Например, чтобы выяснить, не развилась ли эрозия матки, достаточно исследовать мазок.
- Врачи и больницы
- Диеты
- Заболевания и способы лечения
- Здоровый образ жизни
- Лекарственные препараты
- Оборудование и диагностика
©18 TheDifference.ru. 16+
Адрес:г. Санкт-Петербург, ул. Фучика, д 49 Б, оф. 17
Источник: https://thedifference.ru/raznica-mezhdu-gistologiej-i-citologiej/
Ваш дерматолог
Большая медицинская энциклопедия
Авторы: А. С. Петрова; В. И. Алипов
Цитологическое исследование (греч. kytos вместилище, здесь – клетка + logos учение) – исследование, основанное на изучении с помощью микроскопа особенностей строения клеток, клеточного состава органов, тканей, жидкостей организма человека и животных в норме и при патологических процессах .
Цитологическое исследование широко применяется в биологии для изучения закономерностей строения и жизнедеятельности клетки и в медицине – для диагностики различных заболеваний. Методы цитологического исследования, используемые в судебной медицине, позволяют обнаруживать клеточные элементы повреждённых тканей на различных орудиях, транспортных средствах и др.
Отличие цитологического и гистологического исследований
Диагностическое цитологическое исследование сходно с гистологическим исследованием биопсийного материала по цели (прижизненное распознавание патологического процесса), методической основе (морфологический анализ), объекту исследования (компоненты патологических участков органа и ткани), методам окраски ядра, цитоплазмы и других структурных элементов клетки.
Однако при цитологическом исследовании, в отличие от гистологического, требуется значительно меньшее количество материала (отдельные клетки, их комплексы), из которого можно в течение нескольких минут приготовить цитологический препарат (мазок, отпечаток), как правило, без длительной предварительной обработки и не прибегая к помощи специальной аппаратуры.
Вместе с тем материал, подвергаемый цитологическому исследованию, позволяет оценивать изменения лишь на ограниченном участке. Кроме того, в процессе приготовления мазка нарушаются пространственные взаимоотношения компонентов ткани, сохраняющиеся в гистологическом срезе (лишь изредка в цитологическом препарате обнаруживаются небольшие фрагменты ткани). Таким образом, в тех случаях, когда требуется выявить взаимное расположение клеток и межклеточного вещества в исследуемых тканях, цитологическое исследование уступает гистологическому.
Цитологическое исследование предпочтительнее в тех случаях, когда невозможна или нежелательна биопсия , при необходимости детального изучения особенностей структуры клеток, быстрого получения результата (например, при обследовании больного в условиях поликлиники, массовых проф. осмотрах населения).
Различают цитологическое исследование:
- так называемого эксфолиативного материала (мокрота, моча, сок предстательной железы, смывы из различных органов во время эндоскопии, а также из шейки и полости матки, выделения из молочных желез, соскобы и отпечатки с поверхностей эрозий, язв, свищей, ран, жидкость из суставных и серозных полостей, цереброспинальная и амниотическая жидкость);
- пунктатов (материала, полученного при аспирационной диагностической пункции, преимущественно тонкой иглой)
- отпечатков с удаленных тканей, например поверхности свежего разреза оперативно удаленной или взятой для гистологического исследования ткани.
Область применения
С помощью цитологического исследования оценивают состояние эпителия, мезотелия и степень его пролиферации; гормональную активность у женщин; контролируют степень повреждения опухолевых клеток при лечении злокачественных опухолей, изменение гормонального статуса под влиянием гормональной терапии, следят за динамикой заживления ран и др.
Цитологическое исследование широко применяют во время операции для срочного решения диагностических задач (установления природы патологического процесса, выявления метастазов опухоли или её прорастания в окружающие ткани, наличия клеток опухоли в краях операционного разреза и др.). Значение такого исследования особенно велико при необходимости анализа рыхлых, крошащихся масс, костных и обызвествленных тканей или очень мелких очагов, не пригодных для срочного гистологического исследования.
При диагностике заболеваний различных органов применяют алгоритмы цитологических исследований. При этом цитологическое исследование рассматривают как неотъемлемую часть общего комплекса диагностических мероприятий. Задача алгоритма состоит в получении максимальной объективной цитологической информации в кратчайший срок, без вреда для больного, при минимальном числе исследований.
Алгоритм предусматривает необходимость первоочередного применения наиболее безопасных и эффективных способов получения материала, предпочтительность одномоментных комплексных исследований при обязательном учете особенностей течения патологического процесса, соблюдение принципа преемственности информации.
Ожидаемый результат цитологического исследования зависит от того, насколько правильно получен материал (непосредственно из участка поражения или вблизи него, из участка некроза, кровоизлияния и т. д.). Во многих случаях врач-цитолог лично участвует в проведении пункций и других манипуляций, направленных на получение материала для цитологического исследования.
Способ получения материала
Характер и способ получения материала для цитологического исследования определяется локализацией патологического процесса в том или ином органе (ткани).
При заболеваниях кожи с помощью цитологического исследования изучают соскобы и отпечатки с изъязвленной поверхности, пунктаты из патологических образований.
При поражениях мягких тканей и костей, заболеваниях щитовидной железы и органов кроветворения объектом цитологического исследования являются пунктаты из участков поражения. При заболеваниях нервной системы цитологическому исследованию подвергают цереброспинальную жидкость , при заболеваниях глаза – соскобы с поверхности конъюнктивы , пунктаты из стекловидного тела.
При диагностике заболеваний органов дыхания цитологическому исследованию подлежит мокрота , в том числе и мокрота, выделение которой индуцировано ингаляцией трипсина; материал, полученный путём соскоба, аспирации , смыва, пункции , в том числе лимфатических узлов средостения , во время бронхоскопии и трансторакальной пункции.
С целью цитологической диагностики заболеваний органов пищеварения исследуют смывы из пищевода , желудка , двенадцатиперстной кишки , сигмовидной и прямой кишки («слепой» способ); смывы, полученные под визуальным контролем через катетер, подведённый к участку поражения; соскобы с помощью нейлоновой щетки во время эзофагоскопии , гастроскопии , дуоденоскопии , сигмоскопии, ректоскопии ; соскобы и аспирируемый материал из общего желчного и главного панкреатического протоков во время ретроградной эндоскопической панкреатохолангиографии , пунктаты из слюнных желез , печени ; пунктаты, соскобы и отпечатки из различных органов брюшной полости при лапароскопии , асцитическая жидкость, полученная при лапароцентезе .
При диагностике заболеваний молочной железы изучают выделения из соска и пунктаты пальпируемых и выявленных с помощью маммографии и термографии не пальпируемых образований.
При диагностике заболеваний мужских половых органов цитологическому исследованию подвергают пунктаты из яичка и предстательной железы .
Цитологическая диагностика заболеваний органов мочевыделения основана на исследовании выделившейся мочи ; остаточной мочи, полученной из мочевого пузыря катетером; смывов, соскобов, аспирируемого материала, полученных при цистоскопии и ретроградной катетеризации мочеточника и почечной лоханки , пунктата из почки .
Методы обработки материала и окраски цитологических препаратов разнообразны и зависят от цели исследования. Поскольку результат исследования часто основывается на выявлении тонких повреждений ядерных и цитоплазматических структур, необходима уверенность, что эти изменения не являются артефактами, связанными с нарушением методики обработки и окраски материала. На основании исследования адекватного и репрезентативного материала устанавливают цитологический диагноз. При этом учитывают общую картину, обнаруженную в цитологическом препарате, а не только изменения отдельных клеток, принимают во внимание анамнестические, рентгенологические, эндоскопические и другие данные.
Достоверность цитологического исследования
Как и при любом морфологическом исследовании, достоверность цитологического исследования зависит от чувствительности и специфичности метода, правильности и воспроизводимости результатов. В настоящее время повышение достоверности цитологического диагноза обеспечивается с помощью ряда объективных методов. К ним относятся цитохимические методы исследования , включая цито-спектрофотометрию и иммуноцитохимические тесты , морфометрические методы (кариометрия и цитометрия), математические методы (расчет информативности и весовых коэффициентов цитологических признаков).
Для проведения диагностического цитологического исследования часто используют поляризационную микроскопию , фазово-контрастную микроскопию , люминесцентную микроскопию . В некоторых случаях получаемые для цитологического исследования клетки с успехом культивируют в составе тканевой культуры , при этом они образуют те или иные структуры, характерные для определенной ткани, что нередко облегчает решение дифференциально-диагностических задач.
Важное значение имеет унификация и стандартизация критериев цитологического диагноза. Он может быть утвердительным с чётким определением характера заболевания, предположительным, что должно рассматриваться как указание на необходимость дополнительных диагностических исследований, и отрицательным.
Последний не исключает предполагаемого диагноза, особенно при наличии данных других диагностических методов, свидетельствующих в пользу клинического диагноза. Важным методом оценки данных цитологического исследования является также динамическое наблюдение за клиническим течением болезни после установления цитологического диагноза. Эталоном правильности цитологического диагноза в большинстве случаев являются результаты гистологического исследования. При комплексном использовании цитологического и гистологического исследований удается добиться наиболее высокого уровня достоверности морфологического диагноза.
В настоящее время цитологическое исследование все чаще является самостоятельным методом диагностики во многих областях медицины. Ниже дана краткая характеристика особенностей цитологического исследования в онкологии, акушерстве и гинекологии, хирургии.
Цитологическое исследование в онкологии
Цитологическое исследование в онкологии позволяет устанавливать принадлежность клеток к злокачественной опухоли на основании обнаружения в них большинства признаков злокачественности (полиморфизм клеток, ядер, ядрышек, атипия ядер, нарастание числа митозов и др.). Цитологическая картина обычно отражает особенности гистологического строения опухоли, степень её дифференцировки, а иногда и гистогенетические особенности. Цитологическая верификация новообразований базируется на современных гистологических классификациях опухолей с учетом возможностей цитологического метода.
Являясь эффективным методом диагностики на любом этапе прогрессии опухоли , цитологическое исследование позволяет:
- Определить характер и степень пролиферации эпителия, мезотелия, а также наблюдать в динамике за характером клеточных изменений.
- Диагностировать злокачественные опухоли практически любой локализации и клинической стадии (этому способствует развитие эндоскопической техники, позволяющей производить целенаправленное исследование органов, ранее недоступных морфологическому исследованию без операции).
- Устанавливать гистологическую форму доброкачественных и злокачественных опухолей, а также степень дифференцировки злокачественной опухоли, что имеет значение для выбора рационального метода лечения и оценки прогноза заболевания.
- Определять распространённость злокачественной опухоли, констатируя её прорастание в соседние органы, распознавая метастазы в лимфатические узлы и другие органы.
- Оценить чувствительность опухоли к лечебным воздействиям (лучевой терапии, химиотерапии, иммунотерапии), что важно при разработке рациональных методов лечения и динамическом контроле за его результатами.
Цитологические исследования применяются при массовых проф. осмотрах населения с целью раннего выявления предопухолевых заболеваний и опухолей. Для более эффективного использования цитологического исследования в этой области разрабатываются автоматизированные статистические и проточные сканирующие системы, связанные с ЭВМ. Автоматизированный анализ цитологических препаратов способствует объективизации и стандартизации критериев цитологической диагностики.
Цитологическое исследование для установления точного диагноза опухоли осуществляется преимущественно в онкологических учреждениях . При биопсии опухолей различной локализации рационально проводить параллельно с гистологическим цитологическое исследование биопсированного кусочка, что улучшает результаты морфологических исследования опухолей.
Достоверность цитологического исследования при раке желудка, легкого, молочной и щитовидной желез, шейки матки, мочевого пузыря, прямой кишки, при злокачественных опухолях кожи, мягких тканей и костей составляет более 80%. Цитологическое исследование позволяет решать дифференциально-диагностические задачи не только при опухолях, но и при гиперпластических, метапластических, диспластических изменениях эпителия, реактивных и пролиферативных изменениях других тканей, устанавливать характер различных неопухолевых заболеваний.
Цитологическое исследование в акушерстве и гинекологии
Цитологическое исследование в акушерстве и гинекологии проводится с целью изучения клеток эпителия влагалища (кольпоцитологическое исследование), влагалищной части шейки матки, капала шейки матки и слизистой оболочки тела матки, исследования пунктата (или аспирированного материала) из опухолей женских половых органов с целью выявления особенностей гормонального статуса, предопухолевых заболеваний и рака женских половых органов.
Материалом для цитологического исследования служат влагалищные мазки, мазки-отпечатки, смывы из влагалища, поверхностные соскобы со слизистой оболочки женских половых органов, аспирированный материал из эндометрия и тканевые пунктаты (из опухолей яичников и др.). Чаще всего используют кольпоцитологическое исследование влагалищных мазков (метод Папаниколау).
Показаниями к его применению являются различные заболевания женских половых органов, при которых предполагают те или иные гормональные нарушения. Кроме того, кольпоцитологическое исследование используют для установления фаз менструального цикла , диагностики беременности , контроля за её динамикой, выявления угрозы прерывания и перенашивания беременности .
Цитологическая картина влагалищного отделяемого (мазков или смывов) зависит от суммы гормональных воздействий (эстрогенных, гестагенных, андрогенных). Влагалищный мазок состоит из клеток различных слоёв эпителия слизистой оболочки влагалища . В нем иногда встречаются также эндоцервикальные, эндометриальные клетки, эритроциты, многоядерные клетки, продукты ферментативной деятельности клеток (эстеразы, кислая фосфатаза, бета-глюкуронидаза и др.), лейкоциты, палочки Дедерлейна, клеточный детрит.
Мазки берут из заднего или задне-бокового свода влагалища с помощью деревянного шпателя, ватным или марлевым шариком, браншей пинцета или стеклянной пипеткой с резиновым баллоном. У детей и девственниц используют для этой цели желобоватый зонд, можно использовать также ушную ложечку.
За сутки до взятия мазка обследуемая не должна производить какие-либо влагалищные манипуляции и иметь половые сношения. Мазок наносят на стекло, вместе с каплей изотонического раствора хлорида натрия, и затем с помощью другого стекла размазывают её тонким слоем. Фиксацию производят подсушиванием в смеси равных частей 96% этилового спирта и эфира. Для полихромной окраски мазок лучше фиксировать смесью 97% изопропилового спирта (1/2 ч.) и ледяной уксусной кислоты (21/2 ч.).
Существуют простые и сложные методы окраски мазка. К простым методам относят окраску гематоксилин-эозином, раствором метиленового синего, фуксином и по Романовскому-Гимзе . К сложным – полихромную окраску (модифицированный метод Папаниколау-Шора), комбинированные методы окраски, окраску крезиловым фиолетовым.
Для характеристики влагалищного мазка учитывают количественное соотношение клеточных элементов с помощью специальных индексов. Наиболее часто используют кариопикнотический индекс – отношение ороговевших клеток с пикнотичным ядром к общему числу клеток; ацидофильный (эозинофильный) индекс – процент ацидофильных (эозинофильных) клеток по отношению ко всем сосчитанным; базальный индекс – процентное содержание в мазке базофильных клеток и ряд других индексов.
Кольпоцитограмма – сводные данные о характере влагалищного мазка с указанием его реакции, процентного содержания клеток разных слоёв влагалищного эпителия и наличия других элементов, например эритроцитов, гистиоцитов, лейкоцитов и др.
У новорожденных в первые 5 дней жизни под влиянием эстрогенов матери влагалищные мазки состоят преимущественно из промежуточных и базофильных клеток, с 5-го по 8-й день, когда эстрогенная стимуляция со стороны матери ослабевает, происходит десквамация клеток, и в мазке могут появиться эритроциты, с 8-го по 14-й день мазки приобретают атрофический характер, который сохраняется до 8-9-летнего возраста, когда появляются единичные поверхностные базофильные и ацидофильные клетки.
В препубертатном периоде в мазке поверхностные клетки появляются уже в большем количестве. Увеличение ацидофильного индекса – признак скорого наступления первой менструации. Цитологическая картина влагалищного мазка претерпевает изменения также в соответствии с фазами менструального цикла.
Характеризуя влияние гормонов на цитологическую картину влагалищного мазка, можно сказать, что эстрогены оказывают пролиферативное действие, проявляющееся в появлении плоских изолированных клеток поверхностного эпителия. Прогестерон способствует обратному развитию цитологической картины (десквамация, появление промежуточных клеток и их скоплений). А ндрогены вызывают «старение» мазка – пролиферацию базального и отчасти промежуточного слоя.
На цитологическую картину влагалищного мазка оказывают влияние и негормональные факторы (кератинизация влагалища, цервициты, кольпиты, спринцевания, особенно с использованием химических средств, вагинальное применение лекарственных препаратов, колец, внутриматочных противозачаточных средств). Существует зависимость между гистологической картиной слизистой оболочки влагалища и цитологической картиной влагалищного мазка. Имеется также определенная (не менее выраженная) связь цитологической картины влагалищного мазка с изменениями в эндометрии.
Однако некоторые исследователи отмечают известные расхождения между картиной влагалищного мазка и характером изменений в эндометрии, особенно при нарушениях менструального цикла. При необходимости кольпоцитограмма может быть заменена уроцитограммой, так как слизистая оболочка мочевого пузыря претерпевает сходные со слизистой оболочкой влагалища изменения (вследствие общности развития из урогенитального синуса).
Цитологическое исследование в хирургии
Цитологическое исследование в хирургии применяют чаще с целью изучения в динамике раневого экссудата . При этом удается установить характер раневого процесса , проследить эффективность обработки раны и динамику её заживления, оценить, в известной мере, иммунные свойства организма, его местные регенераторные возможности. При трофических язвах появление в препаратах-отпечатках лимфоцитов и моноцитов свидетельствует об эффективности проводимого лечения, хорошем прогнозе; наличие в экссудате большого числа плазматических клеток указывает на затяжное течение процесса.
Разработаны критерии для интерпретации цитологических данных при посттравматических и осложненных послеоперационных ранах, актиномикотических свищах, сифилитических язвах.
Большая медицинская энциклопедия 1979 г.
Реклама, размещённая на сайте «Ваш дерматолог», является одним из источников его финансирования.
Наличие рекламы медицинских центров, лекарств, методов лечения, нельзя расценивать как рекомендацию владельца сайта к их посещению, приобретению или применению.
Последнее обновление страницы: 05.12.2014 Обратная связь Карта сайта
© NAU. При цитировании и копировании материалов убедительная просьба делать активную ссылку на сайт «Ваш дерматолог»
Представленная на сайте информация не должна использоваться для самостоятельной диагностики и лечения
и не может служить заменой очной консультации врача — дерматолога.
Классификация. Современные методы коррекции морщин, применяемые в косметологии.
Источник: https://www.dermatolog4you.ru/stat/bme/c/citologicheskoe-issledovanie.html